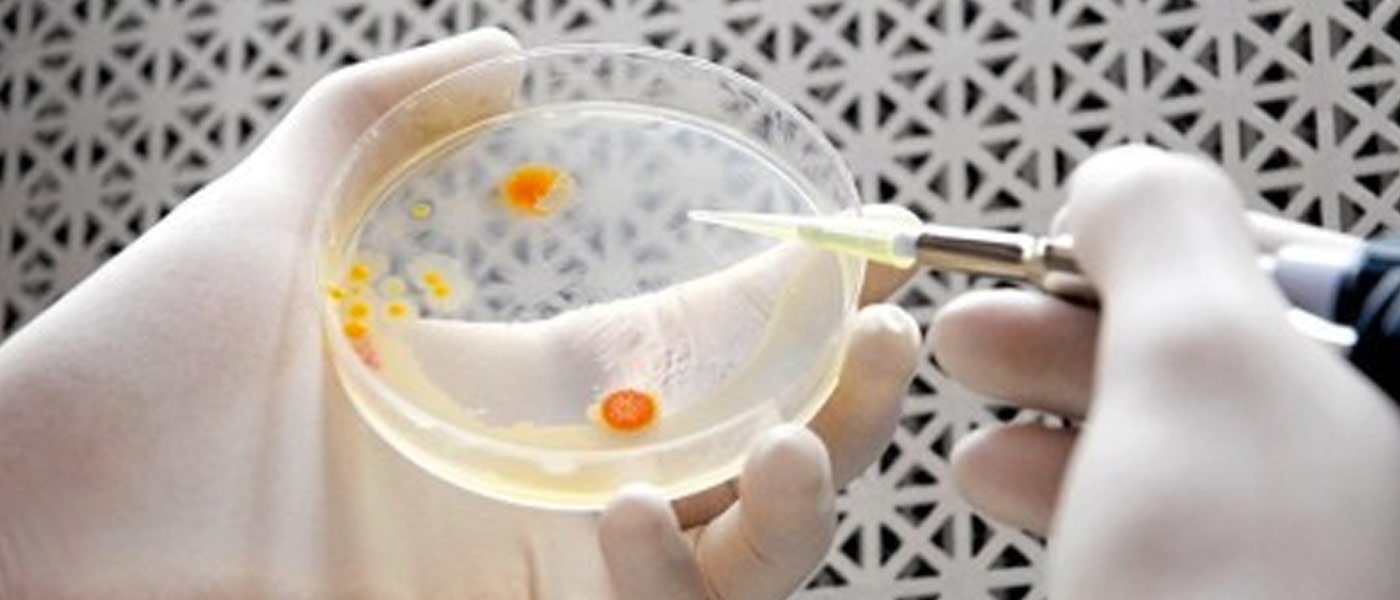

Harvard Professor of Energy, Daniel G. Nocera, was able to genetically engineer bacteria so that it absorbs hydrogen and carbon dioxide to convert into alcohol fuel. The goal was to achieve a significant level of efficiency that could surpass plants. And this month, Nocera announced that his bacteria can convert sunlight 10 times more efficiently than plants.
“Right now we’re making isopropanol, isobutanol, isopentanol,” Nocera said in a lecture to the Energy Policy Institute at Chicago. “These are all alcohols you can burn directly. And it’s coming from hydrogen from split water, and it’s breathing in CO². That’s what this bug’s doing.”

The bacteria, called ralston eutropha, takes hydrogen and CO² then converts it into adenosine triphosphate (ATP) by inserting genes that will allow the ATP to convert to alcohol fuel.
The practical applications of a bacteria that can breathe in CO² and produce energy are unlimited.
With the results of the study soon to be published, Nocera is hoping to get more people excited about how it can continue to be applied for practical purposes.
He makes it a point to explain that this isn’t the solution to the excess C0² in the atmosphere; it can however, help preserve our quickly depleting fossil fuels.